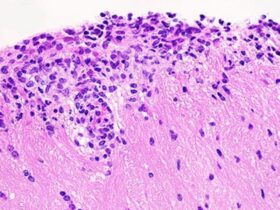
An adaptive cellular source of IL-17A and IL-17F is critical for the induction of experimental autoimmune encephalomyelitis | Science Immunology

Einenkel R, Zygmunt M, Muzzio DO. Microorganisms in the healthy upper reproductive tract: from denial to beneficial assignments for reproductive biology. Reprod Biol. 2019;19:113–8.
Gao H, Lu N, Chen Y, Li G, Li H, Chen I, et al. Endometrial microbiome during early pregnancy among women with and without chronic endometritis: a pilot study. Front Cell Infect Microbiol. 2025;15:1615182.
Li H, Liu L, Wang J, Zhao W. The emerging role of neutrophil extracellular traps in endometritis. Front Immunol. 2023;14:1153851.
Kato T, Kitagawa S. Regulation of neutrophil functions by proinflammatory cytokines. Int J Hematol. 2006;84:205–9.
McLoughlin RM, Witowski J, Robson RL, Wilkinson TS, Hurst SM, Williams AS, et al. Interplay between IFN-gamma and IL-6 signaling governs neutrophil trafficking and apoptosis during acute inflammation. J Clin Investig. 2003;112:598–607.
Liu K, Mao W, Liu B, Li T, Wang X, Pei L, et al. Prostaglandin E2 promotes staphylococcus aureus infection via EP4 receptor in bovine endometrium. Micro Pathog. 2021;158:105019.
Li T, Liu B, Guan H, Mao W, Wang L, Zhang C, et al. PGE2 increases inflammatory damage in Escherichia coli-infected bovine endometrial tissue in vitro via the EP4-PKA signaling pathway. Biol Reprod. 2019;100:175–86.
Yang X, Zhang S, Liu B, Guo L, Gong P, Wu J, et al. Exogenous prostaglandin D(2) as a modulator in bovine endometritis: implications for reducing antibiotic use in dairy cattle. Front Vet Sci. 2025;12:1618203.
Johnson H, Torres CG, Carvallo F, Duchens M, Peralta OA. Endometrial expression of selected transcripts in postpartum of primiparous Holstein cows with clinical and subclinical endometritis. Anim Reprod Sci. 2015;156:34–9.
Herath S, Lilly ST, Santos NR, Gilbert RO, Goetze L, Bryant CE, et al. Expression of genes associated with immunity in the endometrium of cattle with disparate postpartum uterine disease and fertility. Reprod Biol Endocrinol. 2009;7:55.
Yi Y, Nie J, Liu X, Guo SW. Progressively diminished prostaglandin E2 signaling in concordance with increasing fibrosis in the Ectopic endometrium. Reprod Sci. 2025;32:1271–86.
Sakamoto R, Fujiwara T, Kawano Y, Aikawa S, Inazumi T, Nakayama O, et al. Uterine prostaglandin DP receptor, induced upon implantation, contributes to decidualization together with EP4 receptor. J Lipid Res. 2024;65:100636.
Sztachelska M, Ponikwicka-Tyszko D, Sokolowska G, Anisimowicz S, Czerniecki J, Lebiedzinska W, et al. Oxytocin antagonism reverses the effects of high oestrogen levels and oxytocin on decidualization and cyclooxygenase activity in endometrial tissues. Reprod Biomed Online. 2019;39:737–44.
Li W, Wu ZQ, Zhao J, Guo SJ, Li Z, Feng X, et al. Transient protection from heat-stress-induced apoptotic stimulation by metastasis-associated protein 1 in pachytene spermatocytes. PLoS ONE. 2011;6:e26013.
Sen N, Gui B, Kumar R. Physiological functions of MTA family of proteins. Cancer Metastasis Rev. 2014;33:869–77.
Pakala SB, Reddy SDN, Bui-Nguyen TM, Rangparia SS, Bommana A, Kumar R. MTA1 coregulator regulates LPS response via MyD88-dependent signaling. J Biol Chem. 2010;285:32787–92.
Chen JK, Wang WC, Zang L, Zhao J, Li W, Jiang T. Repression of a chromatin modifier aggravates lipopolysaccharide-induced acute lung injury in mouse. Biochem Biophys Res Commun. 2016;471:515–21.
Wang H, Dong BW, Zheng ZH, Wu ZB, Li W, Ding J. Metastasis-associated protein 1 (MTA1) signaling in rheumatoid synovium: regulation of inflammatory response and cytokine-mediated production of prostaglandin E2 (PGE2). Biochem Biophys Res Commun. 2016;473:442–8.
Ghanta KS, Pakala SB, Reddy SD, Li DQ, Nair SS, Kumar R. MTA1 coregulation of transglutaminase 2 expression and function during inflammatory response. J Biol Chem. 2011;286:7132–8.
D’Ippolito S, Tersigni C, Marana R, Di Nicuolo F, Gaglione R, Rossi ED, et al. Inflammosome in the human endometrium: further step in the evaluation of the “maternal side. Fertil Steril. 2016;105:111–8 e1-4.
Cicinelli E, De Ziegler D, Nicoletti R, Colafiglio G, Saliani N, Resta L, et al. Chronic endometritis: correlation among hysteroscopic, histologic, and bacteriologic findings in a prospective trial with 2190 consecutive office hysteroscopies. Fertil Steril. 2008;89:677–84.
Song D, Li TC, Zhang Y, Feng X, Xia E, Huang X, et al. Correlation between hysteroscopy findings and chronic endometritis. Fertil Steril. 2019;111:772–9.
Kobayashi R, Tajika Y, Kohmaru J, Morita S, Horii T, Mizukami Y, et al. The histone methyltransferase KMT2D is essential for embryo implantation via regulating the precise differentiation of endometrial cells. Cell Death Discov. 2024;10:357.
Yu Y, Mao N, Yu L, Lin F, Shi X, Lu X, et al. YiMu-QingGong san alleviates lipopolysaccharide-induced endometritis in mice via inhibiting inflammation and oxidative stress through regulating macrophage polarization. J Ethnopharmacol. 2025;337:118992.
Wu Y, Zhang J, Qin Y. S100A4 promotes the development of lipopolysaccharide-induced mouse endometritis. Biol Reprod. 2018;99:960–7.
Na YR, Yoon YN, Son D, Jung D, Gu GJ, Seok SH. Consistent inhibition of cyclooxygenase drives macrophages towards the inflammatory phenotype. PLoS ONE. 2015;10:e0118203.
Shaukat A, Shaukat I, Rajput SA, Shukat R, Hanif S, Zhang X, et al. Ginsenoside Rb1 mitigates Escherichia coli lipopolysaccharide-induced endometritis through TLR4-mediated NF-kappaB pathway. Molecules 2021;26:7089.
OuYang Z, Hirota Y, Osuga Y, Hamasaki K, Hasegawa A, Tajima T, et al. Interleukin-4 stimulates the proliferation of endometriotic stromal cells. Am J Pathol. 2008;173:463–9.
Stadtmauer DJ, Wagner GP. Single-cell analysis of prostaglandin E2-induced human decidual cell in vitro differentiation: a minimal ancestral deciduogenic signal. Biol Reprod. 2022;106:155–72.
Doi-Tanaka Y, Tamura I, Shiroshita A, Fujimura T, Shirafuta Y, Maekawa R, et al. Differential gene expression in decidualized human endometrial stromal cells induced by different stimuli. Sci Rep. 2024;14:7726.
Xing X, Zhang G, Yi F, Xu X. Overexpression of USP22 ameliorates LPS-induced endometrial stromal cells inflammation and modulates cells decidualization by inhibiting ferroptosis. Reprod Biol. 2024;24:100913.
Makabe T, Koga K, Nagabukuro H, Asada M, Satake E, Taguchi A, et al. Use of selective PGE2 receptor antagonists on human endometriotic stromal cells and peritoneal macrophages. Mol Hum Reprod. 2021;27:gaaa077.
Shao Y, Luo Y, Sun Y, Jiang J, Li Z, Wang Z et al. Leonurine exerts anti-inflammatory effects in lipopolysaccharide (LPS)-induced endometritis by modulating mouse JAK-STAT/PI3K-Akt/PPAR signaling pathways. Genes. 2024;15:857.
Dong YS, Hou WG, Li Y, Liu DB, Hao GZ, Zhang HF, et al. Unexpected requirement for a binding partner of the syntaxin family in phagocytosis by murine testicular Sertoli cells. Cell Death Differ. 2016;23:787–800.
Jin X, Zhang S, Ding T, Zhao P, Zhang C, Zhang Y, et al. Testicular Lmcd1 regulates phagocytosis by Sertoli cells through modulation of NFAT1/Txlna signaling pathway. Aging Cell. 2020;19:e13217.
Kitaya K, Yasuo T. Immunohistochemical and clinicopathological characterization of chronic endometritis. Am J Reprod Immunol. 2011;66:410–5.
Guo J, Chen L, Luo N, Li C, Chen R, Qu X, et al. LPS/TLR4-mediated stromal cells acquire an invasive phenotype and are implicated in the pathogenesis of adenomyosis. Sci Rep. 2016;6:21416.
Zhang C, Lai JH, Hu B, Zhang S, Zhao J, Li W. A chromatin modifier regulates Sertoli cell response to mono-(2-ethylhexyl) phthalate (MEHP) via tissue inhibitor of metalloproteinase 2 (TIMP2) signaling. Biochim Biophys Acta. 2014;1839:1170–82.
Zhang S, Li W, Zhu C, Wang X, Li Z, Zhang J, et al. Sertoli cell-specific expression of metastasis-associated protein 2 (MTA2) is required for transcriptional regulation of the follicle-stimulating hormone receptor (FSHR) gene during spermatogenesis. J Biol Chem. 2012;287:40471–83.
Yu L, Su YS, Zhao J, Wang H, Li W. Repression of NR4A1 by a chromatin modifier promotes docetaxel resistance in PC-3 human prostate cancer cells. FEBS Lett. 2013;587:2542–51.
Wang J, Chitsaz F, Derbyshire MK, Gonzales NR, Gwadz M, Lu S, et al. The conserved domain database in 2023. Nucleic Acids Res. 2023;51:D384–D388.
Millard CJ, Fairall L, Schwabe JW. Towards an understanding of the structure and function of MTA1. Cancer Metastasis Rev. 2014;33:857–67.
Shang W, Xiao Z, Yu Z, Wei N, Zhao G, Zhang Q, et al. Chemical synthesis of the outer core oligosaccharide of Escherichia coli R3 and immunological evaluation. Org Biomol Chem. 2015;13:4321–30.
Li SY, Mi YH, Shen W, Hu XL, Zhang J, Nan F, et al. Two new xanthones from the twigs of Calophyllum membranaceum and their anti-inflammatory activities in HESC cells. Chem Biodivers. 2022;19:e202200355.
Shen W, Ma X, Shao D, Wu X, Wang S, Zheng J, et al. Neutrophil extracellular traps mediate bovine endometrial epithelial cell pyroptosis in dairy cows with endometritis. Int J Mol Sci. 2022;23:14013.
Zeindler J, Angehrn F, Droeser R, Daster S, Piscuoglio S, Ng CKY, et al. Infiltration by myeloperoxidase-positive neutrophils is an independent prognostic factor in breast cancer. Breast Cancer Res Treat. 2019;177:581–9.
Yang M, Liu S, Cai J, Sun X, Li C, Tan M, et al. Bile acids ameliorate lipopolysaccharide-induced endometritis in mice by inhibiting NLRP3 inflammasome activation. Life Sci. 2023;331:122062.
Li L, Qi J, Tao H, Wang L, Wang N, Huang Q. Protective effect of the total flavonoids from Clinopodium chinense against LPS-induced mice endometritis by inhibiting NLRP3 inflammasome-mediated pyroptosis. J Ethnopharmacol. 2023;312:116489.
Poloso NJ, Urquhart P, Nicolaou A, Wang J, Woodward DF. PGE2 differentially regulates monocyte-derived dendritic cell cytokine responses depending on receptor usage (EP2/EP4). Mol Immunol. 2013;54:284–95.
Jana B, Calka J, Bulc M, Witek K. Role of noradrenaline and adrenoreceptors in regulating prostaglandin E2 synthesis cascade in inflamed endometrium of pigs. Int J Mol Sci 2023;24:5856.
Frank GR, Brar AK, Cedars MI, Handwerger S. Prostaglandin E2 enhances human endometrial stromal cell differentiation. Endocrinology. 1994;134:258–63.
Peng-Fei H, Na AR, Hui C, Hong-Yu W, Jin-Shan C. Activation of alpha7 nicotinic acetylcholine receptor protects bovine endometrial tissue against LPS-induced inflammatory injury via JAK2/STAT3 pathway and COX-2 derived prostaglandin E(2). Eur J Pharmacol. 2021;900:174067.
Tsatsanis C, Androulidaki A, Venihaki M, Margioris AN. Signalling networks regulating cyclooxygenase-2. Int J Biochem Cell Biol. 2006;38:1654–61.
Liu J, Li C, Wang J, Xu D, Wang H, Wang T, et al. Chromatin modifier MTA1 regulates mitotic transition and tumorigenesis by orchestrating mitotic mRNA processing. Nat Commun. 2020;11:4455.
Li J, Wei J, Chen S, Wang X, Chen J, Zeng D, et al. Prevalence and risk factors for chronic endometritis in patients with adenomyosis and infertility: a retrospective cohort study. BMC Women’s Health. 2024;24:403.
Hirata T, Narumiya S. Prostanoids as regulators of innate and adaptive immunity. Adv Immunol. 2012;116:143–74.
Lara E, Rivera N, Cabezas J, Navarrete F, Saravia F, Rodríguez-Álvarez L et al. Endometrial stem cells in farm animals: potential role in uterine physiology and pathology. Bioengineering. 2018;5:75.
Mason KL, Rogers LM, Soares EM, Bani-Hashemi T, Erb Downward J, Agnew D, et al. Intrauterine group A streptococcal infections are exacerbated by prostaglandin E2. J Immunol. 2013;191:2457–65.
Banu SK, Lee J, Speights VO Jr., Starzinski-Powitz A, Arosh JA. Selective inhibition of prostaglandin E2 receptors EP2 and EP4 induces apoptosis of human endometriotic cells through suppression of ERK1/2, AKT, NFkappaB, and beta-catenin pathways and activation of intrinsic apoptotic mechanisms. Mol Endocrinol. 2009;23:1291–305.
Nishimura T, Zhao X, Gan H, Koyasu S, Remold HG. The prostaglandin E2 receptor EP4 is integral to a positive feedback loop for prostaglandin E2 production in human macrophages infected with Mycobacterium tuberculosis. FASEB J. 2013;27:3827–36.
Cheng H, Huang H, Guo Z, Chang Y, Li Z. Role of prostaglandin E2 in tissue repair and regeneration. Theranostics. 2021;11:8836–54.
Mitacek MCG, Praderio RG, Stornelli MC, de la Sota RL, Stornelli MA. Endometritis in the bitch: immunohistochemical localization of cyclooxygenase 2. Open Vet J. 2020;10:157–63.
Park YK, Hong H, Jang BC. Transcriptional and translational regulation of COX-2 expression by cadmium in C6 glioma cells. Int J Mol Med. 2012;30:960–6.

Leave a Reply